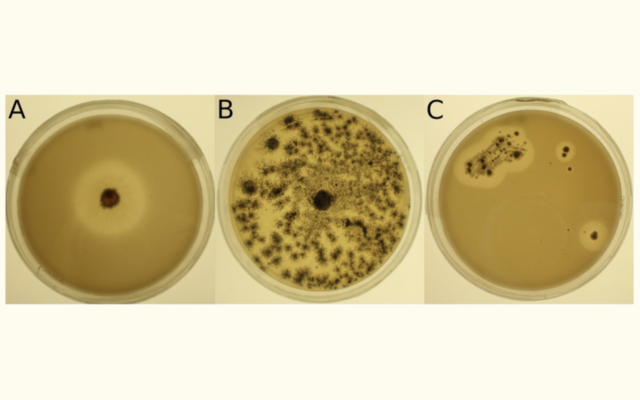

Blog
News, insights, and updates on bioconversion, sustainability, and the circular economy.
Latest
Discover how biodegradable plastic additives perform in various environments. ASTM tests reveal impressive degradation rates in composting, marine, and landfill conditions.

Science
Dec 10, 2024Discover how Biodegradable Future Additives (BFA) outperform other biodegradable plastics. Learn about PLA, PHA, PBAT, and more. Explore...
Science
Dec 10, 2024Learn the 4 phases of plastic biodegradation, from aerobic to methanogenic. Learn how active microbial environments break down...
Monthly insights on bioconversion and the circular economy.